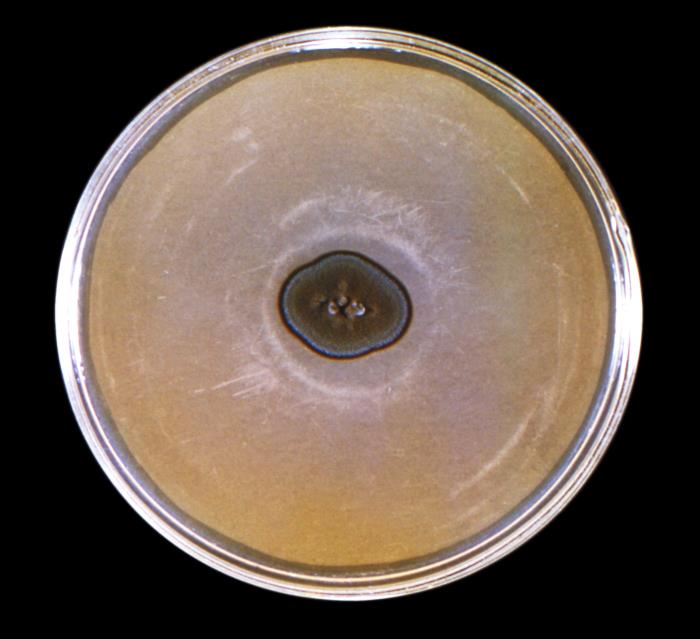
Cladosporium carrionii. CDC Public Health Image Library (PHIL).

Cladosporium es un hongo filamentoso, perteneciente al filo Ascomycota y al grupo de los dematiáceos, caracterizados por presentar una coloración oscura.
Microscópicamente presenta hifas finas, septadas, ramificadas de color hialino a marrón. Las hifas sostienen cadenas ramificadas de conidios unicelulares, elipsoides o cilíndricos, algunos con forma de escudo debido a las cicatrices de unión entre ellos. Los conidios se forman por gemación sucesiva del conidio anterior, estando el conidio más joven y pequeño al final de la cadena.
Macroscópicamente forma colonias aterciopeladas, pulverulentas o vellosas, con pliegues radiales, de color blanco o crema que tienden a oscurecerse en tonos verde oliva y, a veces, gris verdoso o marrones.
Viabilidad, propagación y transmisión
Reservorio
Suelo, vegetación (p.ej. vegetación en descomposición, madera en putrefacción y humus de los bosques), fómites.
Hospedadores
Humanos, bovinos, felinos, cánidos, anfibios, peces, etc.
Dosis Infectiva Mínima (DIM)
Se desconoce en la actualidad.
Supervivencia ambiental
Es un hongo saprófito, normalmente se encuentra colonizando las plantas o en el suelo. Puede crecer en paja y madera húmeda, alimentos, combustibles fósiles, cosméticos (cremas), pinturas, plásticos, papel y tejidos (ropa, alfombras, cuero).
Su temperatura óptima de crecimiento es de 18ºC a 28ºC, la mayoría de las especies no crecen a temperaturas superiores a 35ºC, pero algunas como C. herbarum pueden crecer a bajas temperaturas hasta los -6ºC. Normalmente requieren humedad relativa alta del 80% al 90%, aunque especies como C. carrionii pueden crecer con baja humedad relativa y colonizar plantas xerófilas.
Las esporas se encuentran en forma de bioaerosol en el aire, principalmente a finales de verano y principios de otoño, sobre todo en zonas templadas, siendo un contaminante habitual en los edificios o en los lugares de trabajo.
Formas de resistencia
Esporas.
Mecanismo de propagación y transmisión
La transmisión se produce principalmente por contaminación de heridas o por inoculación del hongo mediante pinchazos o arañazos con herramientas o elementos contaminados como paja, astillas, etc.
También la inhalación de las esporas o conidios presentes en forma de bioaerosol en ambientes laborales se ha relacionado con procesos de alergia, con infecciones en el sistema respiratorio y con efectos tóxicos, como el síndrome tóxico por polvo orgánico (ODTS).
En muy raras ocasiones la ingesta de alimentos contaminados (cereales almacenados a bajas temperaturas) se ha relacionado con intoxicaciones alimentarias.
A veces, se les relaciona con casos de enfermedad nosocomial, principalmente por contaminación de heridas quirúrgicas.
Vías de entrada
Respiratoria. Percutánea. Digestiva.
Distribución geográfica
Mundial (algunas especies predominan en zonas de clima tropical y subtropical, sin embargo, C. carrionii crece principalmente en zonas de clima árido o semiárido).
Efectos sobre la salud
Grupo de riesgo
Sin clasificar.
(Ver Anexo II RD 664/1997 )Infección
Feohifomicosis: micosis cutáneas y subcutáneas, que afectan principalmente a personas inmunocomprometidas, como consecuencia de la inoculación accidental o de la contaminación de heridas por el hongo. Las manifestaciones clínicas suelen ser lesiones de desarrollo lento, en el mismo sitio donde se produjo la herida o traumatismo, normalmente en las extremidades expuestas: brazos, manos, piernas, pies, ojos (queratitis), abdomen, etc.
Cromoblastomicosis, cromomicosis o dermatitis verrugosa: infección cutánea y subcutánea por la inoculación accidental de C. carrionii. Se produce normalmente en climas tropicales y, rara vez, en climas templados y fríos. La lesión al principio consiste en una pápula pequeña, elevada, eritematosa y no pruriginosa. Después, en la misma zona o en áreas adyacentes, aparecen otras lesiones y atrofia del tejido; aumenta la descamación y en la piel se aprecia una coloración rojiza a grisácea. Al cabo de varios años, se observan lesiones pedunculadas y verrugosas, con aspecto de florecillas de coliflor y pequeñas úlceras, que pueden estar cubiertas de material hemato-purulento. En esta etapa, en el tejido infectado se encuentran las estructuras fúngicas conocidas como “células escleróticas, células muriformes, monedas de cobre o esclerotes de Mediar”.
Además de la forma verrugosa, existe una segunda forma clínica de la enfermedad, de tipo anular, aplanado o papular, con un borde activo elevado. El centro de esta lesión cicatriza. Estas lesiones son normalmente infectadas por bacterias, lo que conlleva la producción de un exudado purulento, con olor fétido.
En la mayoría de casos la infección se limita a la zona de la lesión y alrededores. No hay invasión de huesos o músculos. En raras ocasiones puede presentarse diseminación hematógena.
También, aunque en escasas ocasiones, se han descrito casos de infecciones pulmonares, sinusitis, onicomicosis, etc. causadas por diferentes especies de Cladosporium, como C. sphaerospermum y C. cladosporioides.
Efectos alérgicos (Ver Anexo II RD 664/1997 ) / (Ver Allergen )
C. hebarum y C. cladosporioides son de los hongos alergénicos respiratorios más importantes en climas templados y fríos, están implicados en casos de rinitis o fiebre del heno, asma, neumonitis por hipersensibilidad y, con menor frecuencia, en casos de urticaria crónica y eczema atópico. También se ha asociado a C. sphaerospermum con alergias respiratorias (3) (9) (13).
Efectos tóxicos (Ver Anexo II RD 664/1997 )
La exposición por vía respiratoria a elevadas cantidades de polvo orgánico, en el que puede haber diferentes hongos, entre ellos Cladosporium, se ha asociado al síndrome tóxico por polvo orgánico (ODTS, fiebre del grano, micotoxicosis pulmonar) (9).
Algunas especies de Cladosporium se han relacionado con efectos tóxicos por vía digestiva como C. herbarum que puede producir ácido epicladospórico, micotoxina implicada en leucopenia tóxica alimentaria por la ingestión de cereales contaminados y C. cladosporioides que puede producir cladosporina y emodina (mutagénica y citotóxica) (6) (9) (13).
Efectos cancerígenos (Ver International Agency for Research On Cancer - IARC )
No se han descrito
Efectos en la maternidad
No se han descrito
Enfermedad
| CIE-10 | Nombre | Enfermedad de Declaración Obligatoria |
|---|---|---|
| B43 | Cromomicosis y absceso feomicótico | No |
Actividades laborales con riesgo
Clasificación Nacional de Actividades Económicas (CNAE)
| CNAE 2009 | Descripción |
|---|---|
| A0111 | Cultivo de cereales, distintos de arroz, leguminosas y oleaginosas |
| A0113 | Cultivo de hortalizas, raíces y tubérculos |
| A0114 | Cultivo de caña de azúcar |
| A0116 | Cultivo de plantas para fibras textiles |
| A0130 | Propagación de plantas |
| A0141 | Explotación de ganado bovino para la producción de leche |
| A0142 | Explotación de otro ganado bovino y búfalos |
| A0143 | Explotación de caballos y otros equinos |
| A0144 | Explotación de camellos y otros camélidos |
| A0145 | Explotación de ganado ovino y caprino |
| A0146 | Explotación de ganado porcino |
| A0148 | Otras explotaciones de ganado |
| A0150 | Producción agrícola combinada con la producción ganadera |
| A0161 | Actividades de apoyo a la agricultura |
| A0162 | Actividades de apoyo a la ganadería |
| A0163 | Actividades de preparación posterior a la cosecha y tratamiento de semillas para reproducción |
| A0170 | Caza, captura de animales y servicios relacionados |
| A0210 | Silvicultura y otras actividades forestales |
| A0220 | Explotación de la madera |
| A0230 | Recolección de productos silvestres, excepto madera |
| E3600 | Captación, depuración y distribución de agua |
| E3700 | Recogida y tratamiento de aguas residuales |
| E3811 | Recogida de residuos no peligrosos |
| F4211 | Construcción de carreteras y autopistas |
| F4212 | Construcción de vías férreas de superficie y subterráneas |
| F4213 | Construcción de puentes y túneles |
| F4221 | Construcción de redes para fluidos |
| F4291 | Obras hidráulicas |
| F4299 | Construcción de otros proyectos de ingeniería civil n.c.o.p. |
| F4312 | Preparación de terrenos |
| F4313 | Perforaciones y sondeos |
| G4623 | Comercio al por mayor de animales vivos |
| N7210 | Investigación y desarrollo experimental en ciencias naturales y técnicas |
| N7500 | Actividades veterinarias |
| O8130 | Actividades de jardinería |
| R8699 | Otras actividades sanitarias n.c.o.p. |
| S9122 | Actividades de sitios históricos y monumentos |
| S9141 | Actividades de los jardines botánicos y los parques zoológicos |
| T9630 | Pompas fúnebres y actividades relacionadas |
Clasificación Nacional de Ocupaciones (CNO)
| CNO 2011 | Descripción |
|---|---|
| 2130 | Veterinarios |
| 2210 | Profesores de universidades y otra enseñanza superior (excepto formación profesional) |
| 2421 | Biólogos, botánicos, zoólogos y afines |
| 2432 | Ingenieros en construcción y obra civil |
| 2454 | Ingenieros geógrafos y cartógrafos |
| 2462 | Ingenieros técnicos de obras públicas |
| 2483 | Ingenieros técnicos en topografía |
| 2821 | Sociólogos, geógrafos, antropólogos, arqueólogos y afines |
| 3122 | Técnicos en construcción |
| 3141 | Técnicos en ciencias biológicas (excepto en áreas sanitarias) |
| 3313 | Técnicos en anatomía patológica y citología |
| 3314 | Técnicos en laboratorio de diagnóstico clínico |
| 3327 | Ayudantes de veterinaria |
| 5892 | Empleados de pompas fúnebres y embalsamadores |
| 5993 | Agentes forestales y medioambientales |
| 6110 | Trabajadores cualificados en actividades agrícolas (excepto en huertas, invernaderos, viveros y jardines) |
| 6120 | Trabajadores cualificados en huertas, invernaderos, viveros y jardines |
| 6201 | Trabajadores cualificados en actividades ganaderas de vacuno |
| 6202 | Trabajadores cualificados en actividades ganaderas de ovino y caprino |
| 6203 | Trabajadores cualificados en actividades ganaderas de porcino |
| 6205 | Trabajadores cualificados en la avicultura y la cunicultura |
| 6209 | Trabajadores cualificados en actividades ganaderas no clasificados bajo otros epígrafes |
| 8331 | Operadores de maquinaria de movimientos de tierras y equipos similares |
| 9511 | Peones agrícolas (excepto en huertas, invernaderos, viveros y jardines) |
| 9512 | Peones agrícolas en huertas, invernaderos, viveros y jardines |
| 9520 | Peones ganaderos |
| 9530 | Peones agropecuarios |
| 9543 | Peones forestales y de la caza |
| 9601 | Peones de obras públicas |
| 9602 | Peones de la construcción de edificios |
| 9603 | Peones de la minería, canteras y otras industrias extractivas |
| 9811 | Peones del transporte de mercancías y descargadores |
Prevención y control
Desinfectantes
Alcoholes, yodóforos, glutaraldehído al 2% y formaldehído.
Inactivación física
Inactivación con calor húmedo a 121ºC durante al menos 15 minutos.
Antimicrobianos
Itraconazol, voriconazol, posaconazol, anfotericina B, terbinafina y 5-fluorocitosina.
Vacunación
No disponible
Medidas preventivas generales
Disponer de ventilación adecuada en los lugares de trabajo, evitar la humedad relativa alta y las condensaciones. Evitar plantas de interior decorativas.
Orden y limpieza en el lugar de trabajo. Implantar un programa periódico de limpieza y mantenimiento de locales, instalaciones y equipos, especialmente en el sistema de climatización-ventilación del edificio.
Almacenar alimentos, residuos orgánicos, paja, madera, cereales, etc. en condiciones relativamente secas y en recintos bien ventilados para prevenir el enmohecimiento.
Evitar procesos pulvígenos o que generen bioaerosoles. Si no es posible, cerramiento o aislamiento de dichos procesos o disponer de un sistema de extracción localizada.
Reducir el uso de herramientas cortantes o punzantes, en caso necesario, utilizarlas con las debidas precauciones y protecciones.
Higiene personal, mantener la piel limpia y seca, lavado de manos después de tocar materiales o elementos potencialmente contaminados. Utilizar ropa y calzado de trabajo que cubra la mayor parte del cuerpo.
Limpieza y desinfección de cortes, arañazos o heridas en la piel, evitar el contacto de las mismas con elementos contaminados. Cubrir las heridas con apósitos estériles e impermeables.
Precauciones en centros sanitarios
En hospitales o centros sanitarios, adoptar las Precauciones Estándar (12).
EPI
Protección respiratoria: mascarillas autofiltrantes por lo menos FFP2, o máscaras con filtros P2 en tareas que puedan generar bioaerosoles o polvo.
Protección ocular o facial: gafa de protección de montura universal en caso de riesgo de contacto accidental mano/guante contaminado-ojo, o pantalla de protección facial (símbolo de marcado en montura: 3) en caso de riesgo de exposición a salpicaduras, o gafa de protección de montura integral con hermeticidad frente a partículas (símbolo de marcado en montura: 4), en caso de riesgo de exposición a polvo.
Protección de las manos: guantes impermeables en la manipulación de materiales contaminados (heno, paja enmohecida).
Seguridad en laboratorio
Nivel de contención: 2
El riesgo de contraer la infección en laboratorio es bajo. El principal riesgo es la inoculación accidental o contaminación de heridas; también se producen efectos alérgicos por inhalación de bioaerosoles contaminados.
Las muestras más peligrosas son los cultivos del hongo, las muestras procedentes del suelo y las de los materiales o especímenes contaminados.
Se requieren las prácticas y las medidas de contención de un nivel 2 de bioseguridad. Evitar el empleo de material cortante o punzante. Utilizar cabina de seguridad biológica clase II en aquellas operaciones que impliquen la generación de bioaerosoles, proyecciones o salpicaduras; también usar guantes impermeables en la manipulación o el contacto con muestras contaminadas.
Bibliografía
- Koneman, E. W., & Roberts, C. D. (1987). Micología práctica de laboratorio. Editorial Médica Panamericana.
- Peña, J. (1983). Micología clínica: Técnicas de diagnóstico de las micosis. Editorial Ciencia.
- Pontón, J., Moragues, M. D., Gené, J., Guarro, J., & Quindós, G. (2002). Hongos y actinomicetos alergénicos. Revista Iberoamericana de Micología.
- Romero, R. (2007). Microbiología y parasitología humana. Editorial Médica Panamericana.
- Rubio, M. C., Gil, J., Benito, T. R., Ramírez de Ocáriz, I., & Navarro, M. (2007). Micosis más frecuentes en nuestro medio. En Guía práctica de identificación y diagnóstico en micología clínica (2ª ed.) (Capítulo 2). Revista Iberoamericana de Micología.
- Tasic, S., & Miladinovic, N. (2007). Cladosporium spp. – cause of opportunistic mycoses. Acta Facultatis Meicae Naissensis, 24(1), 15-19.
- Centers for Disease Control and Prevention (CDC). (2020). Biosafety in microbiological and biomedical laboratories (6th ed.).
- Comisión de Salud Pública del Consejo Interterritorial del Sistema Nacional de Salud. Ministerio de Sanidad y Consumo. (2000). Protocolo de vigilancia sanitaria específica para los/as trabajadores/as expuestos a Asma Laboral.
- Institut National de Santé Publique du Québec. (2002). Les risques à la santé associés à la présence de moisissures en milieu intériur.
- Instituto Nacional de Seguridad e Higiene en el Trabajo (INSHT). (2014). Guía técnica para la evaluación y prevención de los riesgos relacionados con la exposición a agentes biológicos (2ª ed.).
- Instituto Nacional de Seguridad y Salud en el Trabajo (INSST). Notas Técnicas de Prevención (NTP): 288, 299, 313, 335, 488, 539, 802 y 901.
- Servicio Riojano de Salud. (2008). Precauciones de aislamiento en centros sanitarios.
- Thermo Fisher Scientific. (2021). Cladosporium herbarum. Allergy & autoinmune disease: Allergen encyclopedia.